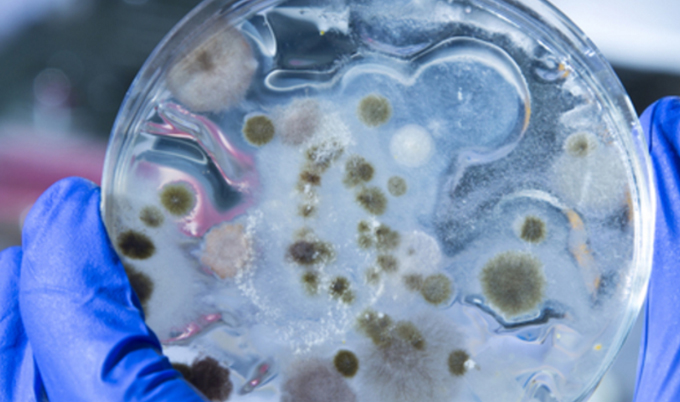

Bacteria that hold clues to the origins of life
Comment: The bacteria that hold clues to the origins of life
Published on: 4 October 2016
Writing for The Conversation, Professor Jeff Errington discusses how the bacterial cell wall can help us understand how pathogens evade our defences and how key antibiotics such as penicillin work.
Animalcules, antibiotics and the bacteria that hold clues to the origins of life
Antonie van Leeuwenhoek, the 18th-century Dutch scientist, was the first person to see single-celled organisms through a microscope and describe what he called “animalcules”. Three centuries later we’ve learned a great deal about microorganisms such as bacteria, as a source of deadly diseases, industrial enzymes and wonderful wines and beers. We have also learned much about their design. Recent work on some of the most important structures in bacteria and what happens when we interfere with them, has even illuminated how the first lifeforms on Earth may have emerged.
Bacteria are single-celled organisms and the cell wall that surrounds their plasma membrane, is made from a polymer (rather like a mesh) of amino acids and sugars. This wall is a crucial structure for bacterial shape and division, which makes it a good target for antibiotics. Elements of it also trigger powerful immune responses against infections. So studying the cell wall can help us understand how pathogens evade our defences and how key antibiotics such as penicillin work, which might in turn inform us about how antibiotic resistance might arise and help us to keep our best antibiotics safe from overuse.
Seeing is believing
About 100 years ago, the invention of gram staining, which uses special dyes to stain the cell wall, revealed at least two major classes of bacteria: gram-positive and gram-negative. Both include nasty pathogens, including resistant Staphylococcus aureus (MRSA) and E.coli.

But it is only recently, with advances in microscopic imaging methods, that we now see bacteria as immensely complex bio-machines. The average bacterium, for example, is capable of making about 5,000 different proteins, which form most of the important structures of the cell and carry out the majority of functions. FtsZ, the master regulator of division, forms an amazing ring structure at the precise centre of the cell, and MreB, which determines the cylindrical shape of the cell wall, forms arcs running around the edge of the cell.
Many bacteria are “rod” shaped, with two hemispherical caps or “poles”, and they grow by elongating this cylinder shape. To replicate, the cell grows inward, and then they divide – relying on that amazing FtsZ machine - always precisely at the mid-point of the cell. The whole process is incredibly efficient and it’s very rare to find cells that fail to divide properly.
The cell wall, which acts as a huge sac-like molecule that covers the whole cell surface, is really important in this growth and division. It’s a tough material but it also has to be capable of being enlarged continuously to enable growth, and then has to be precisely and elaborately moulded to enable cell division.
The invention of the cell wall was a key step in enabling bacteria to spread across the planet in the early phase of life on earth and virtually all modern bacteria have a wall made of more or less the same material. It must have evolved very early and the machinery responsible for making the wall has remained essentially unchanged since then.
L-form bacteria and the origins of life
For all the importance of this wall, then, it is a surprise that many bacteria are able to switch almost effortlessly into a cell-wall deficient “L-form” state. Not only do they become completely resistant to many antibiotics in this state but they may also be able to pass under the radar screen of our immune systems.
These special bacteria have been implicated in many chronic or persistent diseases but they are difficult to study as they are so fragile and slow growing. We wanted to know much more about their basic biology so began working with our favourite lab bacterium, Bacillus subtilis. Although they are difficult to culture, with some technical tricks we worked out how to do it – and found that it’s surprisingly easy to generate the switch that turns them from normal bacteria to L-forms.
Our first remarkable finding was that these bacteria become completely independent of the normally essential division machinery. Instead, they use a strange and seemingly haphazard process, forming tubes that split into multiple small cells, or blebbing, in which bulges in the membrane extrude and detach to form new cells. This happens because they make an excess amount of membrane, which increases their surface area relative to volume.
Understanding the strange behaviour of L-form bacteria might even give us insights into early simpler lifeforms. Many scientists are trying to work out how life might have evolved and there are plausible ideas for how the early steps may have taken place. After the first chemical building blocks accumulated and RNA developed to store information and act as a catalyst (followed later by DNA and proteins), there needed to be a container of some kind – the creation of the first cells, with replication-enabling enzymes inside – for natural selection to happen. The invention of a structure that replicators could surround themselves with to protect their “goods” would have been a key step in evolution. In modern cells, this structure is the complex plasma membrane supported by the cell wall.
At about the same time that we were uncovering the strange replication mechanism for L-forms, theoretical scientists and biophysicists were pondering how simple membrane sacs could be divided. They showed that all you need to do to a very simple membrane sac is increase its surface area, avoiding any leaks. If the surface area to volume ratio increases, the sacs undergo spontaneous changes in shape and even divide. This test-tube form of division looks remarkably similar to what we discovered the L-forms were doing. So, as it turns out, our work looking at bacteria has revealed a surprisingly simple mechanism for replication that may be a hangover from those used by some of the first cells on the planet.
Jeff Errington, Director of the Centre for Bacterial Cell Biology, Newcastle University
This article was originally published on The Conversation. Read the original article.



